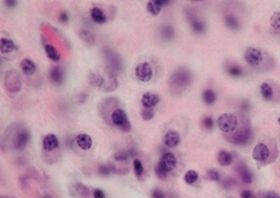
A korszerű terápiáknak köszönhetően az elmúlt években egyre jobban kezelhetővé vált a mielóma multiplex, a csontvelő plazmasejtes daganatos betegsége.

A terápiás lehetőségeket tekintve Közép-Európa és a Baltikum Nyugat-Európa mögött jár.
Vezető szakpolitikusok és egészségügyi szakértők gyűltek össze a múlt héten Prágában, hogy megoldást találjanak a daganatos betegek ellátásában tapasztalható regionális különbségekre. Bejelentették, hogy a közép-európai és a balti államokban a csontvelő plazmasejtes daganatos betegségéről (mielóma multiplex) első alkalommal készül átfogó elemzés az Economist Impact vezetésével.
Az eseményt – a korábbi sikeres kezdeményezések nyomán – a pozsonyi székhelyű stratégiai tanácsadó szervezet, a GLOBSEC hívta életre azzal a céllal, hogy előmozdítsa az együttműködést az egészségügyben. A rendezvényen a daganatos betegek ellátásában rejlő kihívások és lehetőségek, elsősorban az Európai Unió rákellenes tervében (Europe’s Beating Cancer Plan) felvázolt vívmányok és stratégiák kerültek napirendre különös tekintettel a mielóma multiplexre, valamint a Közép- és Nyugat-Európa közötti „ellátási különbségekre”.
„Az Európai Bizottság több mint 4 milliárd eurót különített el az európai rákellenes tervre, amelynek célja, hogy javítsa a rákbetegek ellátásának a minőségét, elősegítse hozzáférésüket az innovatív terápiákhoz, továbbá támogassa az új gyógymódok fejlesztését. A vérképzőszervi daganatos betegségek, különösen a mielóma multiplex kezelése lehet a jó példája és pilotja annak, hogyan vegyük sikeresen kézbe a daganatos betegellátás kérdését, és hogyan érjünk el viszonylag rövid idő alatt pozitív eredményeket” – mondta el Robert Babeľa professzor, a Szlovák Orvostudományi Egyetem rektorhelyettese.
„A régióban az egészségügyi kiadások GDP-arányosan és egy főre vetítve is jelentősen alacsonyabbak, mint Nyugat-Európában, a GDP-arányos egészségügyi kiadások az EU27 átlagától (2019-ben 9,9%) is elmaradnak.”
A GLOBSEC egészségügyi felkészültségi indexe (GLOBSEC’s Health Care Readiness Index) megerősíti ezeket az adatokat, és Közép-Európát és a Baltikumot általános felkészültsége szempontjából az unió átlaga, valamint Norvégia és Nagy-Britannia mögé sorolja. A frissített index bemutatásával „a GLOBSEC célja, hogy hozzájáruljon az egészségügyi ellátás felkészültségéről szóló vitákhoz, valamint elősegítse az együttműködést a daganatos betegségek elleni küzdelemben” – mutatta be az aktuális adatokat Martin Smatana, a GLOBSEC munkatársa.
A mielóma multiplex egyre fiatalabb generációkat érint. Európában 2020-ban mintegy 51.000 embert diagnosztizáltak mielóma multiplexszel.[2] Közép-Európában és a Baltikumban a mielóma új terápiás lehetőségeihez való hozzáférés elmarad a nyugat-európaitól, és a betegség kezelésére vonatkozó naprakész, országspecifikus terápiás irányelvek hiánya azt jelzi, hogy a betegek számára elérhető terápiás lehetőségek nem optimálisak. Bár az elmúlt két évtizedben a mielóma multiplex terápiája kapcsán több mint 3000 klinikai vizsgálat zajlott le, csupán 6%-ukban vettek részt közép- és kelet-európai betegek.
A régióban számos tényező hátráltatja a klinikai vizsgálatokat: a regisztráció nem kellően hatékony folyamata, a képzett munkaerő hiánya, a standard terápiákhoz való hozzáférés nehézsége, valamint az ellátás heterogenitása.
Emellett gyakori, hogy a betegséget késve diagnosztizálják; a diagnózis felállításakor a betegek több mint felénél már súlyosabb tünetek és szövődmények jelentkeznek (a régióban a betegek 56%-ánál csontbetegség, 51%-ánál vérszegénység is kialakul), amelyek még nagyobb terhet rónak rájuk, és az ellátórendszerre.
Az ellátásban tapasztalható különbségek felszámolásáról a következő hat hónapban átfogó regionális tanulmány készül az Economist Impact független kutatása alapján. Ez a nagyszabású elemzés mélyebb betekintést nyújt majd a betegség elleni küzdelem régiós helyzetébe.
„A betegellátás átalakítása szükséges ahhoz, hogy a régióban eredményesebbé váljon a mielómakezelés, és javuljanak a betegek kilátásai. Ez magában foglalja, hogy javuljon a hozzáférés a korai diagnózishoz, az autológ őssejt-transzplantációhoz és az innovatív terápiákhoz” – hangsúlyozta Gerard Dunleavy, az Economist Impact vezető tanácsadója.
Az év elején a mielóma multiplexszel élő betegek már hallatták a hangjukat A remény perspektívája – élet a mielóma multiplexszel című dokumentumfilmben, a készülő elemzés pedig az egészségügyben érdekelt szereplőket szólítja meg.
Ahogy Mira Armour, a MijelomCRO társalapítója és vezetője fogalmazott: „Az a küldetésünk, hogy a régiónkban minden beteg biztonságban érezze magát; tudja, hogy jó kezekben van, és idejében megkapja a legmodernebb terápiákat. Ez ad motivációt a munkámban, és biztos vagyok abban, hogy sikerrel járunk.”
Mielóma multiplex: ezért fontos a korai diagnózis
Kövesse az Egészségkalauz cikkeit a Google Hírek-ben, a Facebook-on, az Instagramon vagy a X-en,Tiktok-on is!